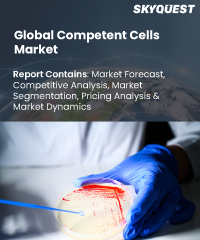
Global Competent cells Market

Report ID: SQSG35H2024

Report ID: SQSG35H2024
sales@skyquestt.com
USA +1 351-333-4748
Report ID:
SQSG35H2024 |
Region:
Global |
Published Date: November, 2025
Pages:
157
|Tables:
88
|Figures:
76



Global Competent Cells Market size was valued at USD 2.3 Billion in 2024 and is poised to grow from USD 2.49 Billion in 2025 to USD 4.64 Billion by 2033, growing at a CAGR of 8.1% during the forecast period (2026–2033).
Competent cells are bacterial cells that take extrachromosomal DNA and plasmids. The ability to integrate foreign DNA is a characteristic of E. coli. Calcium chloride and heat shock are used to render the cell walls of these organisms permeable. Calcium chloride is used to chill the germs to zero degrees Celsius, and they are then promptly heated for 90 seconds at 47 degrees Celsius. While the heat process provides a temperature gradient that creates a space aiding the DNA to enter the Competent Cells, the calcium chloride treatment counteracts the repulsive action of phospholipid heads in the membrane. The transformation process uses these cells.
Global competent cells market is further impacted by the growth of public and private sector investments in molecular cloning research and the development in consumer demand for molecularly cloned goods. Additionally, expanding government activities in the form of funding, population expansion, an increase in healthcare spending, consumer knowledge of the products, and an increase in healthcare spending all favourably impact the global competent cells market.
US Competent Cells Market is poised to grow at a sustainable CAGR for the next forecast year.
Market snapshot - 2026-2033
Global Market Size
USD 2.13 billion
Largest Segment
Chemically Competent Cells
Fastest Growth
Electro Competent Cells
Growth Rate
8.1% CAGR
To get more insights on this market click here to Request a Free Sample Report
Global Competent Cells Market is segmented by Type, Application, End User and region. Based on Type, the market is segmented into Chemically Competent Cells and Electrocompetent Cells. Based on Application, the market is segmented into Cloning, Subcloning & Routine Cloning, Phage Display Library Construction, Toxic/Unstable DNA Cloning, High-throughput Cloning, Protein Expression, Other Applications, Mutagenesis, Single-stranded DNA Production, Lentiviral Vector Production and Large Plasmid Transformation. Based on End User, the market is segmented into Pharmaceutical and Biotechnology Companies, Academic Research Institutes and Contract Research Organizations (CROs). Based on region, the market is segmented into North America, Europe, Asia Pacific, Latin America and Middle East & Africa.
Based on type, it is anticipated that throughout the anticipated period, the Chemically Competent Cells segment will account for the greatest market share. Because Electro Competent Cells are appropriate for numerous molecular biology applications, such as the creation of cDNA libraries, and because they have high transformation efficiencies, this market is predicted to grow at the greatest CAGR.
Based on end user, it is projected that the Pharmaceutical & Biotechnology Companies sector would account for the biggest market share. The considerations have led to an increase in research spending on products based on genomes and proteomics.
To get detailed segments analysis, Request a Free Sample Report
Global competent cells market is dominated by North America and Europe because of the region's large recombinant treatment research efforts and the region's rapid technological advancement. Because of the expanding number of research activities, as well as the surge in investment by major players for manufacturing and research activities in nations like India, Asia-Pacific is anticipated to experience the greatest growth rate during the projected period.
Increased government investment in research and development in Latin American, Middle East and African countries is expected to accelerate the use of competent cells during the forecast period.
To know more about the market opportunities by region and country, click here to
Buy The Complete Report
Favorable Government Initiatives to Drive Market Growth
High Cost to Hamper Market Growth
Request Free Customization of this report to help us to meet your business objectives.
Global Competent cells Market is highly competitive and somewhat fragmented. To maintain a competitive edge, the major industry participants are continually implementing various growth strategies. Innovations, mergers, and acquisitions, collaborations and partnerships are adopted by these players to thrive in the competitive market. In order to provide industries with the most effective and economical solutions, the major market players are also continually concentrating on R&D.
SkyQuest's ABIRAW (Advanced Business Intelligence, Research & Analysis Wing) is our Business Information Services team that Collects, Collates, Co-relates, and Analyses the Data collected utilizing Primary Exploratory Research backed by the robust Secondary Desk research.
According to our global competent cells market analysis, in terms of type, the chemically competent cells segment held the largest market share. In terms of end user, the Pharmaceutical & Biotechnology Companies segment dominates the market. Moreover, global market is anticipated to grow at a steady rate over the forecast years due to rising consumer demand for items made using recombinant DNA technology and advances in molecular engineering. Whereas, industry limitations are likely to be caused by things like entrance hurdles brought on by market consolidation and the high price of kits.
| Report Metric | Details |
|---|---|
| Market size value in 2024 | USD 2.3 Billion |
| Market size value in 2033 | USD 4.64 Billion |
| Growth Rate | 8.1% |
| Base year | 2024 |
| Forecast period | 2026-2033 |
| Forecast Unit (Value) | USD Billion |
| Segments covered |
|
| Regions covered | North America (US, Canada), Europe (Germany, France, United Kingdom, Italy, Spain, Rest of Europe), Asia Pacific (China, India, Japan, Rest of Asia-Pacific), Latin America (Brazil, Rest of Latin America), Middle East & Africa (South Africa, GCC Countries, Rest of MEA) |
| Companies covered |
|
| Customization scope | Free report customization with purchase. Customization includes:-
|
To get a free trial access to our platform which is a one stop solution for all your data requirements for quicker decision making. This platform allows you to compare markets, competitors who are prominent in the market, and mega trends that are influencing the dynamics in the market. Also, get access to detailed SkyQuest exclusive matrix.
Table Of Content
Executive Summary
Market overview
Parent Market Analysis
Market overview
Market size
KEY MARKET INSIGHTS
COVID IMPACT
MARKET DYNAMICS & OUTLOOK
Market Size by Region
KEY COMPANY PROFILES
Methodology
For the Competent Cells Market, our research methodology involved a mixture of primary and secondary data sources. Key steps involved in the research process are listed below:
1. Information Procurement: This stage involved the procurement of Market data or related information via primary and secondary sources. The various secondary sources used included various company websites, annual reports, trade databases, and paid databases such as Hoover's, Bloomberg Business, Factiva, and Avention. Our team did 45 primary interactions Globally which included several stakeholders such as manufacturers, customers, key opinion leaders, etc. Overall, information procurement was one of the most extensive stages in our research process.
2. Information Analysis: This step involved triangulation of data through bottom-up and top-down approaches to estimate and validate the total size and future estimate of the Competent Cells Market.
3. Report Formulation: The final step entailed the placement of data points in appropriate Market spaces in an attempt to deduce viable conclusions.
4. Validation & Publishing: Validation is the most important step in the process. Validation & re-validation via an intricately designed process helped us finalize data points to be used for final calculations. The final Market estimates and forecasts were then aligned and sent to our panel of industry experts for validation of data. Once the validation was done the report was sent to our Quality Assurance team to ensure adherence to style guides, consistency & design.
Analyst Support
Customization Options
With the given market data, our dedicated team of analysts can offer you the following customization options are available for the Competent Cells Market:
Product Analysis: Product matrix, which offers a detailed comparison of the product portfolio of companies.
Regional Analysis: Further analysis of the Competent Cells Market for additional countries.
Competitive Analysis: Detailed analysis and profiling of additional Market players & comparative analysis of competitive products.
Go to Market Strategy: Find the high-growth channels to invest your marketing efforts and increase your customer base.
Innovation Mapping: Identify racial solutions and innovation, connected to deep ecosystems of innovators, start-ups, academics, and strategic partners.
Category Intelligence: Customized intelligence that is relevant to their supply Markets will enable them to make smarter sourcing decisions and improve their category management.
Public Company Transcript Analysis: To improve the investment performance by generating new alpha and making better-informed decisions.
Social Media Listening: To analyze the conversations and trends happening not just around your brand, but around your industry as a whole, and use those insights to make better Marketing decisions.
REQUEST FOR SAMPLE
Want to customize this report? This report can be personalized according to your needs. Our analysts and industry experts will work directly with you to understand your requirements and provide you with customized data in a short amount of time. We offer $1000 worth of FREE customization at the time of purchase.
Feedback From Our Clients